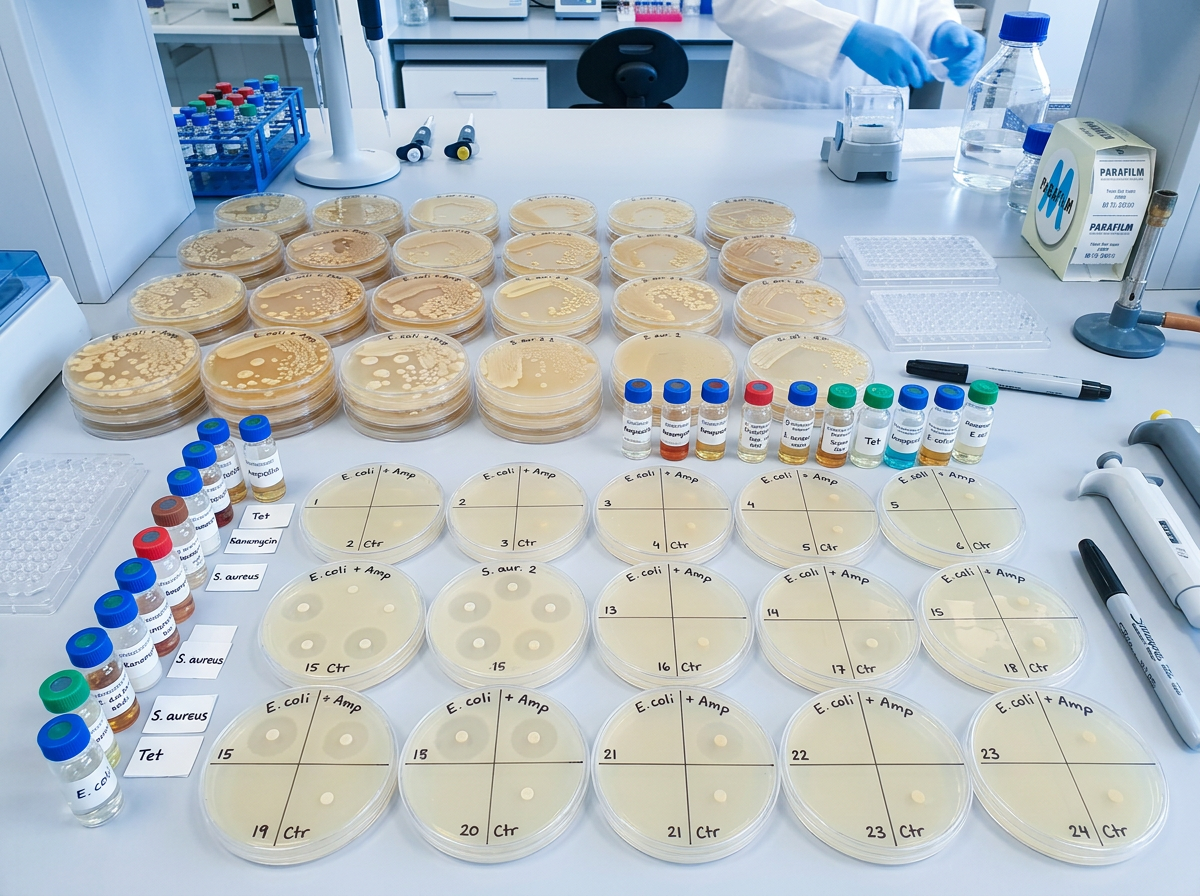
Laboratory petri dishes showing gut bacteria growth inhibited by chemical contaminants

You probably washed your strawberries this morning. You might have even bought the organic ones. But a team of researchers at the University of Cambridge just demonstrated that at least 168 chemicals routinely found in everyday products, from the herbicide on your lawn to the flame retardant in your couch cushions, can damage or kill the beneficial bacteria living in your gut. Some of those chemicals do something even more alarming: they train surviving bacteria to resist antibiotics. The study, published in Nature Microbiology in November 2025, is the largest screening of environmental chemicals against human gut bacteria ever conducted, and the findings suggest that the chemical exposures most of us consider routine may be quietly undermining one of the most important systems in our bodies.
This research arrives at a moment when scientists are also learning that gut bacteria are far more active participants in our health than previously understood. A separate study from the Max Planck Institute, published in Proceedings of the National Academy of Sciences, revealed that beneficial gut microbes possess sophisticated chemical sensing systems that allow them to detect nutrients, communicate with neighboring species, and maintain the delicate ecosystem that keeps us healthy. When industrial chemicals disrupt that ecosystem, the consequences may reach far beyond your digestive tract.
What the Cambridge Study Found
The research team at Cambridge’s MRC Toxicology Unit, led by Professor Kiran Patil and first author Dr. Indra Roux, systematically tested 1,076 different chemical contaminants against 22 species of human gut bacteria under controlled laboratory conditions. Of those chemicals, 829 were pesticides, including herbicides, insecticides, and fungicides. The remainder included industrial compounds used in manufacturing, flame retardants added to furniture and electronics, and plasticizers found in food packaging and consumer goods.
The results identified 168 chemicals that inhibited the growth of at least one bacterial species. That number alone is concerning, but the specifics paint an even more troubling picture. Three chemicals stood out for their breadth of destruction. Hexachlorophene, a fungicide and antibacterial agent, inhibited 20 of the 22 bacterial strains tested. Tetrabromobisphenol A (TBBPA), a flame retardant present in electronics and textiles, inhibited 19 strains. Closantel, an antiparasitic drug used in livestock, also inhibited 19 strains. These are not obscure laboratory compounds. They are substances that millions of people encounter through food residues, household products, and environmental contamination.
“We’ve found that many chemicals designed to act only on one type of target, say insects or fungi, also affect gut bacteria,” Dr. Roux explained. “We were surprised that some of these chemicals had such strong effects.” The surprise is warranted. Current chemical safety testing protocols do not require manufacturers to evaluate how their products affect human gut bacteria. The Cambridge study makes a strong case that they should.
Perhaps the most disturbing finding was that some bacteria, when exposed to these chemicals, developed resistance mechanisms that also made them resistant to ciprofloxacin, a widely prescribed antibiotic. This means routine chemical exposure could be contributing to the antibiotic resistance crisis through a pathway that regulators have not yet considered.
How Gut Bacteria Sense Their World
To understand why chemical disruption matters so much, you need to appreciate how sophisticated your gut bacteria actually are. Research published in August 2025 by Victor Sourjik’s team at the Max Planck Institute for Terrestrial Microbiology, along with collaborators at Ohio State University and Philipps-University Marburg, revealed that beneficial gut microbes, particularly species in the Clostridia group, possess an elaborate network of chemical sensors. These sensors allow bacteria to detect and navigate toward nutrient sources, communicate with other microbial species, and respond to changes in their local environment.
The team, led by first author Wenhao Xu, systematically screened the chemical receptors of commensal gut bacteria and identified previously unknown sensory domains. These sensors respond to an unexpectedly wide range of metabolic compounds, including breakdown products from carbohydrates, fats, proteins, DNA, and amines. Among all the compounds tested, lactate (lactic acid) and formate (formic acid) emerged as the most frequently detected stimuli, suggesting these molecules function as primary nutrient signals that guide bacteria toward food sources within your intestines.
“These domains appear to be important for interactions between bacteria in the gut,” Xu noted. The research also revealed a process called cross-feeding, where one bacterial species releases metabolites like lactate that other species use as nutrition. This cooperative behavior helps stabilize the entire gut ecosystem. When environmental chemicals kill or disable certain species, the cross-feeding network breaks down, and the cascade of consequences can affect bacterial populations that were never directly exposed to the chemical in the first place.
The findings also help explain why gut health affects so many seemingly unrelated body systems. Your gut bacteria use these sensory mechanisms to produce approximately 90% of your body’s serotonin, along with GABA, dopamine, and other neurotransmitters. They regulate immune function, synthesize vitamins, and maintain the intestinal barrier that prevents toxins from entering your bloodstream. Chemicals that impair bacterial sensing don’t just reduce microbial diversity; they compromise the communication network that connects gut health to brain function, immune response, and metabolic regulation.
The Chemical Exposure You Cannot See
The challenge with environmental chemical exposure is that most of it is invisible. You cannot taste the pesticide residues on conventionally grown produce, smell the flame retardants off-gassing from your furniture, or feel the plasticizers leaching from food packaging into your lunch. Yet the cumulative burden is substantial. The average American encounters dozens of synthetic chemicals daily through food, water, air, and skin contact.
Pesticides represent the most direct route to your gut bacteria. When you eat conventionally grown fruits and vegetables, you ingest trace amounts of herbicides like glyphosate and diquat, fungicides, and insecticides that survive washing and digestion to reach your lower intestine. The Cambridge study tested many of these specific agricultural chemicals and found that fungicides, as a category, showed the highest rates of antimicrobial activity against gut bacteria. This makes biological sense: fungicides are designed to kill microorganisms, and bacteria are close enough relatives that the toxic mechanisms often cross over.
Flame retardants like TBBPA present a different exposure route. These chemicals are embedded in electronics, upholstered furniture, carpeting, and building insulation. They leach into household dust, which you inhale and inadvertently ingest. Children, who spend more time on floors and put objects in their mouths, face especially high exposure levels. The fact that TBBPA inhibited 19 of 22 gut bacteria strains in the Cambridge study raises serious questions about what chronic, low-level exposure does to developing microbiomes.
Plasticizers, including compounds like bisphenol A (BPA) and various phthalates, migrate from food packaging, water bottles, and storage containers into the food and beverages they hold. Heat accelerates this process, which is why microwaving food in plastic containers or leaving water bottles in hot cars dramatically increases exposure. These compounds are already under scrutiny for their endocrine-disrupting effects, and the Cambridge data now adds gut microbiome disruption to the list of concerns.

Your Gut Bacteria Shape How Food Heals You
The chemical assault on gut bacteria becomes even more concerning when you consider recent findings about how microbes process the beneficial compounds in food. Research led by Professor Gianni Panagiotou at the University of Jena and the Leibniz Institute for Natural Product Research, published in Nature Microbiology in December 2025, demonstrated that gut bacteria are responsible for converting plant-based phytonutrients into their active, health-promoting forms. The study analyzed 775 distinct phytonutrients from edible plants and found that approximately 70% of all microbiome enzymes participate in processing these plant compounds.
That statistic reframes the entire conversation about healthy eating. When you consume a serving of blueberries, broccoli, or turmeric, your body depends on specific bacterial enzymes to convert the raw phytonutrients into bioavailable compounds that actually deliver health benefits. If the bacteria responsible for those enzymatic conversions have been damaged or eliminated by chemical exposure, you may be eating all the right foods without receiving their full protective effects. It is the biological equivalent of having a state-of-the-art kitchen with no chef.
“Our results show how important microbiome function is for the effects of healthy nutrition,” Professor Panagiotou stated. His team’s analysis of more than 5,500 human microbiomes from across the globe found that bacterial enzyme composition varies significantly between individuals based on genetics, geography, and dietary patterns. Patients with chronic diseases, including inflammatory bowel disease, colorectal cancer, and non-alcoholic fatty liver disease, showed substantially diminished enzyme capacity for nutrient processing compared to healthy controls. This creates a vicious cycle: chemical exposure damages gut bacteria, damaged bacteria process nutrients less effectively, poor nutrient processing contributes to chronic disease, and chronic disease further depletes the microbiome.
The research also revealed that the bacterial enzymes involved in phytonutrient conversion are not redundant. Different bacterial species handle different categories of plant compounds, so losing even a few species to chemical toxicity can create specific nutritional blind spots. This connects directly to the fibermaxxing trend gaining popularity in 2026: eating more diverse fiber feeds a broader range of bacterial species, but that strategy only works if those species are still alive and functioning in your gut.
The Bigger Picture: Chemicals, Microplastics, and Cumulative Burden
The Cambridge findings do not exist in isolation. They fit into a growing body of evidence showing that modern chemical exposure is degrading human health through multiple overlapping mechanisms. Microplastics, which are now detected in virtually every human tissue sampled, carry their own chemical payloads. Many plastic particles contain the same plasticizers and flame retardants identified in the Cambridge study, meaning that microplastic contamination in food and water is not just a physical hazard but also a delivery system for gut-toxic chemicals.
PFAS compounds, the so-called “forever chemicals” found in nonstick cookware, food packaging, and water supplies, add yet another layer. While the Cambridge study did not specifically test PFAS, earlier research has shown that these persistent chemicals alter gut microbial composition and immune function. When you combine pesticide residues, plasticizers, flame retardants, PFAS, and microplastic-associated chemicals, the total chemical burden on your gut microbiome is likely far greater than any single study can capture.
This cumulative exposure model has significant implications for the organic versus conventional food debate. Organic produce carries substantially lower pesticide residues, and the Cambridge data now provides a specific mechanism by which those residues cause harm. A 2023 study in Environmental Research found that switching to an organic diet for just one week reduced urinary pesticide metabolites by 60-95%, suggesting that dietary choices can meaningfully reduce gut-toxic chemical exposure in a short timeframe. The argument for organic food has always centered on what pesticides do to your endocrine system; the microbiome data adds a second, equally compelling reason.
However, organic food alone cannot solve the problem. Flame retardants in your home, plasticizers in your water supply, and industrial contaminants in your environment all bypass dietary choices entirely. Professor Patil and his team at Cambridge recognized this limitation and developed a machine learning model that can predict the gut microbiome effects of new chemicals before they reach the market. “The real power of this large-scale study is that we now have the data to predict the effects of new chemicals, with the aim of moving to a future where new chemicals are safe by design,” Patil said. That regulatory vision is promising, but it requires policymakers to treat gut health as a legitimate safety endpoint, something no major regulatory agency currently does.
Dr. Stephan Kamrad, another member of the Cambridge team, put it plainly: “Safety assessments of new chemicals for human use must ensure they are also safe for our gut bacteria, which could be exposed to the chemicals through our food and water.” Until that happens, the responsibility falls on individuals to reduce their own exposure while supporting their microbiome through diet and lifestyle choices.

Rebuilding and Protecting Your Gut Microbiome
The encouraging news within this research is that gut bacteria are resilient. While chemical exposure can damage microbial populations, the gut microbiome has a demonstrated capacity to recover when the source of damage is reduced and supportive nutrients are provided. The key is a two-pronged approach: minimize chemical exposure while actively feeding and supporting the bacteria you still have.
Dietary strategies form the foundation of microbiome recovery. The phytonutrient research from Panagiotou’s team confirms that diverse plant intake supports a wider range of bacterial species. Aiming for 30 or more distinct plant foods per week, a target endorsed by the American Gut Project, provides the variety of fibers, polyphenols, and phytonutrients that different bacterial species need. Fermented foods like kefir, sauerkraut, kimchi, and yogurt introduce live bacterial cultures that can replenish depleted populations. Research has shown that combining kefir with prebiotic fiber produces stronger anti-inflammatory effects than either component alone, precisely because the synbiotic combination restores both the bacteria and their food supply simultaneously.
Specific nutrients also support microbiome resilience against chemical stress. Polyphenols from berries, green tea, dark chocolate, and olive oil have been shown to selectively promote beneficial bacterial growth while inhibiting pathogenic species. Butyrate, a short-chain fatty acid produced when bacteria ferment dietary fiber, strengthens the intestinal barrier and reduces the permeability that allows chemicals to reach deeper bacterial communities. Foods rich in resistant starch, including cooked and cooled potatoes, green bananas, and legumes, are particularly effective butyrate promoters.
Beyond diet, practical steps to reduce chemical exposure in your daily environment can meaningfully lower the burden on your microbiome. The following strategies are supported by the research discussed in this article and by broader environmental health guidelines:
- Choose organic for high-pesticide produce. The Environmental Working Group’s “Dirty Dozen” list identifies the conventionally grown fruits and vegetables with the highest pesticide residues. Prioritizing organic versions of these specific items offers the best return on investment.
- Replace plastic food storage with glass or stainless steel. This eliminates a primary source of plasticizer exposure, especially for foods that are heated or stored for long periods.
- Ventilate your home regularly. Opening windows and using HEPA air purifiers reduces indoor concentrations of flame retardant dust and volatile chemical compounds.
- Filter your drinking water. Activated carbon filters remove many pesticides and industrial chemicals, while reverse osmosis systems provide more comprehensive filtration including PFAS removal.
- Wash produce thoroughly. While washing does not eliminate all pesticide residues, studies show it removes 60-80% of surface contaminants. A dilute baking soda solution (one teaspoon per two cups of water) is more effective than plain water.
- Avoid microwaving food in plastic containers. Heat dramatically accelerates the migration of plasticizers into food. Transfer meals to ceramic or glass before reheating.
Your Action Plan
The research from Cambridge, the Max Planck Institute, and the University of Jena collectively tell a story that is both sobering and actionable. Industrial and agricultural chemicals are damaging your gut bacteria through mechanisms that current safety regulations do not account for. Those bacteria, in turn, are sophisticated organisms that sense their environment, communicate with each other, and perform the enzymatic work that converts your healthy diet into actual health benefits. When chemicals disrupt this system, the effects cascade from your gut to your immune system, your brain, your metabolism, and your ability to benefit from the food you eat.
The science points clearly toward two parallel priorities. First, reduce your chemical exposure through practical, incremental changes in how you buy food, store food, and manage your home environment. You do not need to overhaul your life overnight. Start with the highest-impact changes: filtering your water, switching to glass food storage, and buying organic versions of the most heavily sprayed produce. Second, actively support your microbiome through dietary diversity, fermented foods, and adequate fiber intake. A gut microbiome that receives consistent nutritional support recovers faster and resists chemical damage more effectively.
The regulatory changes that Professor Patil envisions, where new chemicals must prove they are safe for gut bacteria before reaching the market, may take years to materialize. In the meantime, you have the information and the tools to protect yourself. Your gut bacteria have been quietly working for you since the day you were born. It is worth returning the favor.
Sources
- Everyday chemicals are quietly damaging beneficial gut bacteria - ScienceDaily, January 2026. Reporting on the Cambridge MRC Toxicology Unit study published in Nature Microbiology.
- Gut bacteria can sense their environment and it’s key to your health - ScienceDaily, February 2026. Reporting on Sourjik et al., Proceedings of the National Academy of Sciences.
- The power of gut enzymes: Why healthy eating affects everyone differently - Medical Xpress, December 2025. Reporting on Zhang et al., Nature Microbiology.
- Common pesticides and plastic chemicals stifle healthy gut bacteria - The New Lede, November 2025. Investigative reporting on the Cambridge chemical screening study.
- Pesticides and other common chemical pollutants are toxic to our ‘good’ gut bacteria - University of Cambridge, 2025. Official press release with researcher quotes and methodology details.






